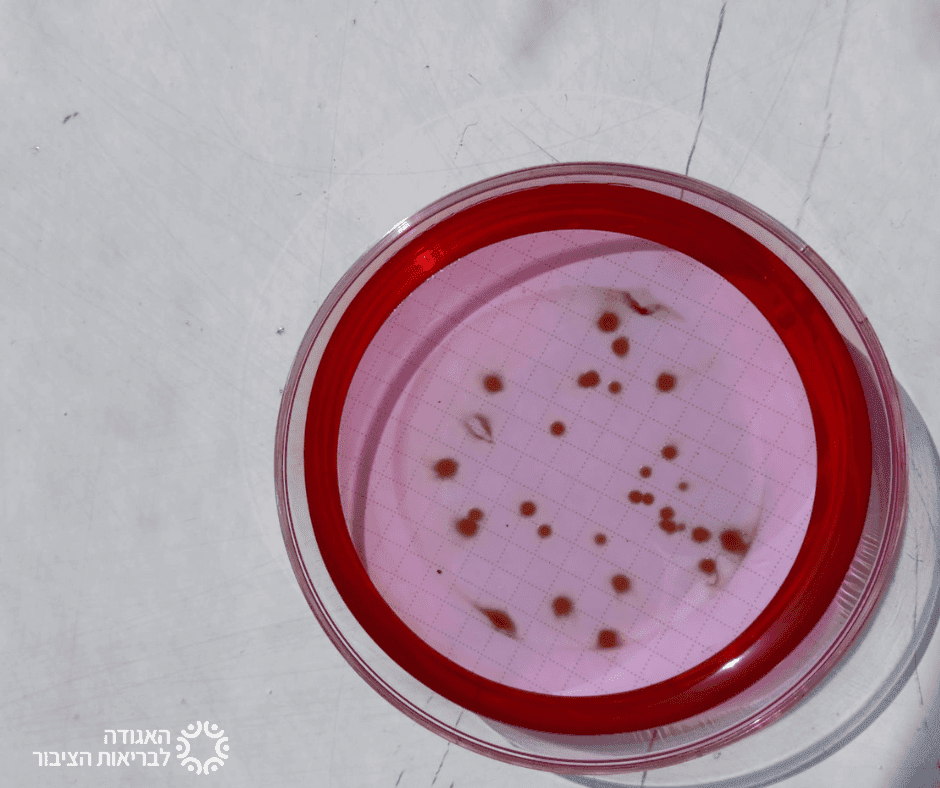
מעבדה

המעבדה למיקרוביולוגיה של המים באגודה לבריאות הציבור היא מעבדה ותיקה ומוערכת. המעבדה ביצעה הקיץ בחודשים יולי אוגוסט יותר בדיקות מאי פעם, 10400 ! בדיקות לאיתור חיידקים במים. ערכנו בדיקות במים של בתי אבות, בתי חולים, מלונות, בנייני מגורים, מקוואות ובריכות שחיה.
מידי קיץ המעבדה בודקת פעמיים בחודש את כל בריכות השחייה ופארקי המים של לקוחותינו וזאת על מנת לאתר זיהומי חיידקים במים ולמנוע תחלואה. צוות מחלקת הדיגום במעבדה מנטר את רמות הכלור, העכירות וטמפרטורת המים ומעדכן את מפעילי הבריכות בכל חריגה.
דוגמאות המים מגיעות למעבדה לבדיקה לאיתור חיידקים מחוללי מחלות. בין החיידקים הנבדקים קבוצת הקוליפורמים שמעידים על זיהום צואתי במים וחיידקי הסטאפילוקוקים שמעידים כי רוחצים עם פצעים נכנסו לבריכה. הימצאות חיידקים אלו עלולים לגרום לזיהומי מעיים, עור, אוזניים וגרון את המתרחצים.
לשמחתנו, הרוב הגדול של הבדיקות היה תקין, כלומר הבריכות היו נקיות ובטוחות לרחצה. יחד עם זאת היו מקרים מעטים של בריכות שחיה ופארקי מים שהתגלו בהם חיידקים מסוכנים. במקרים כאלה המידע הועבר למשרד הבריאות ולמפעילי הבריכות והליקויים תוקנו במהרה. אנו עושים הכל ומידי יום להבטיח את בריאות הציבור.
שחיה נעימה
תיאור תמונות:
תמונה מימין- מושבות קוליפורמים
תמונת אמצע- מושבות פסאודומונס
תמונה משמאל- צוות המעבדה למיקרוביולוגיה של מים